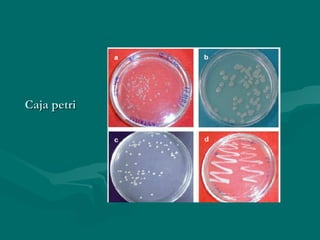
Caja petri

El documento habla sobre la importancia de la toma, transporte y análisis de muestras para el diagnóstico microbiológico. Se debe seleccionar la muestra apropiada del lugar de infección, en el momento oportuno y en la cantidad adecuada. Es necesario el uso de técnicas asépticas, rotular correctamente la muestra e identificar al paciente, y transportar y conservar la muestra de forma que permita la supervivencia de los posibles organismos, para evitar errores en el diagnóstico.